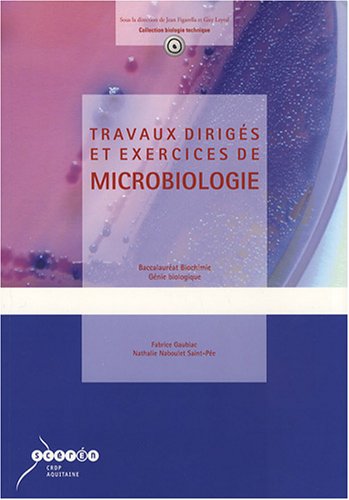
Travaux dirigés et exercices de microbiologie : Bac Biochimie Génie biologique en ligne Travaux dirigés et exercices de microbiologie : Bac Biochimie Génie biologique en ligne

Vous cherchez endroit pour lire pleins E-Books sans téléchargement? Ici vous pouvez lireTravaux dirigés et exercices de microbiologie : Bac Biochimie Génie biologique telecharger. Vous pouvez également lire et télécharger les nouveaux et anciens E-Books complètes . Profitez-en et vous détendre en lisant complète Travaux dirigés et exercices de microbiologie : Bac Biochimie Génie biologique Livres en ligne.
biologie
